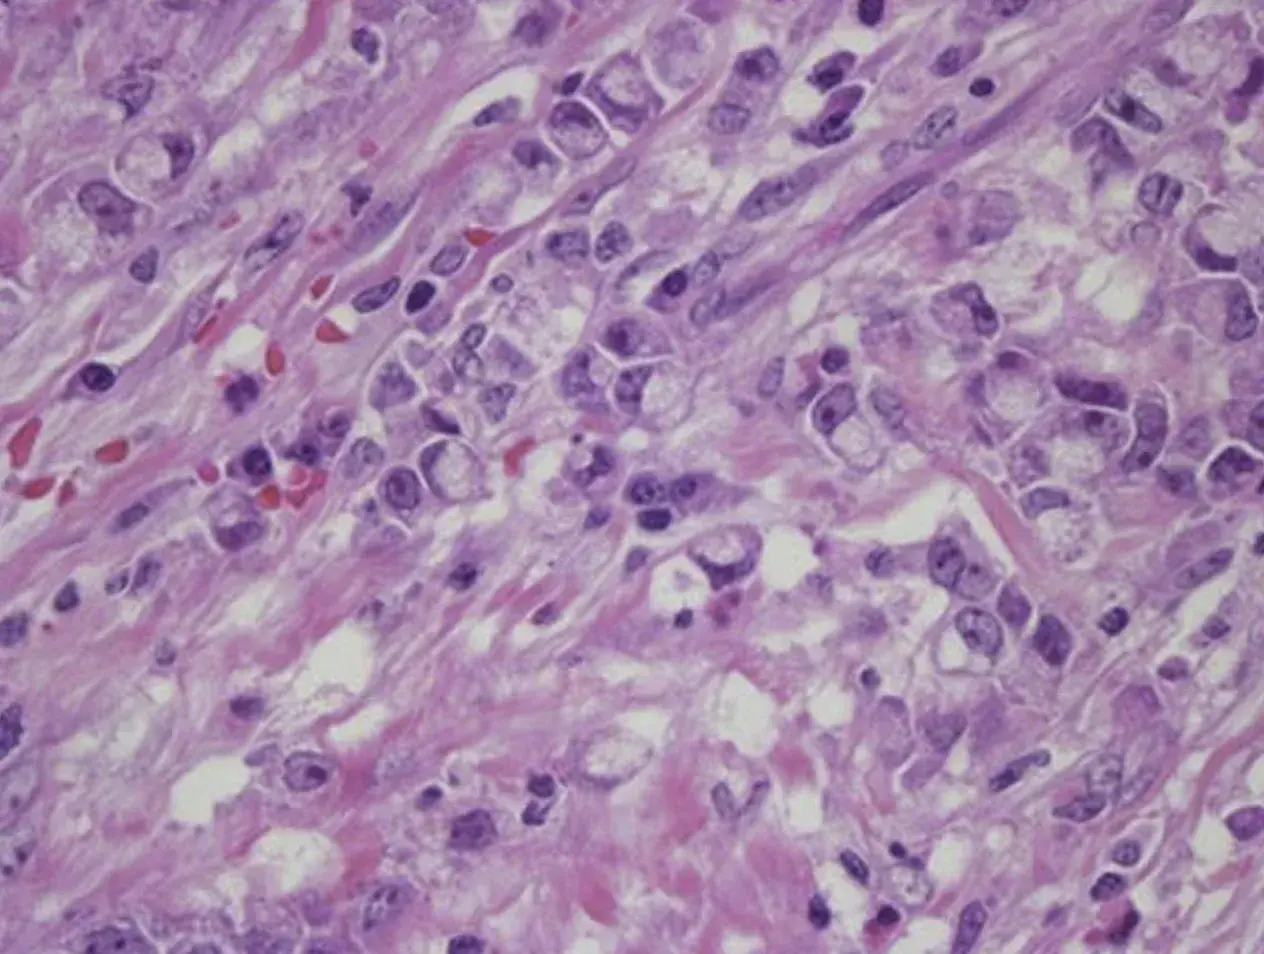

Surgical Pathology
Surgical Pathology is CHI-Creighton Pathology Department’s most comprehensive diagnostic service, reflecting the expertise of our highly qualified physicians. Our board-certified pathologists are experts in most subspecialty areas including breast pathology, gastrointestinal and hepatic pathology, gynecologic and reproductive pathology, genitourinary pathology, and neuropathology, among others.
CHI Hospitals and clinics provide an impressively wide variety of surgical pathology specimen for examination by our pathologists. Two main types of surgical pathology specimens we receive include biopsies and surgical resections. Pathology analysis of these biopsy and surgical resection specimens is the gold standard to confirm a diagnosis and stage the extent of malignant disease. The other major function of the surgical pathology division is to perform rapid intraoperative consultations (frozen section or gross examination) to assist surgeons in determining the appropriate course of action during surgical procedures. Subspecialty expertise of our pathologists allows for increased experience and skill for the interpretation of challenging cases. These cases also provide excellent learning opportunity for our residents and medical students.
Pic: Gastric signet ring cell carcinoma in a 59-year old male patient.